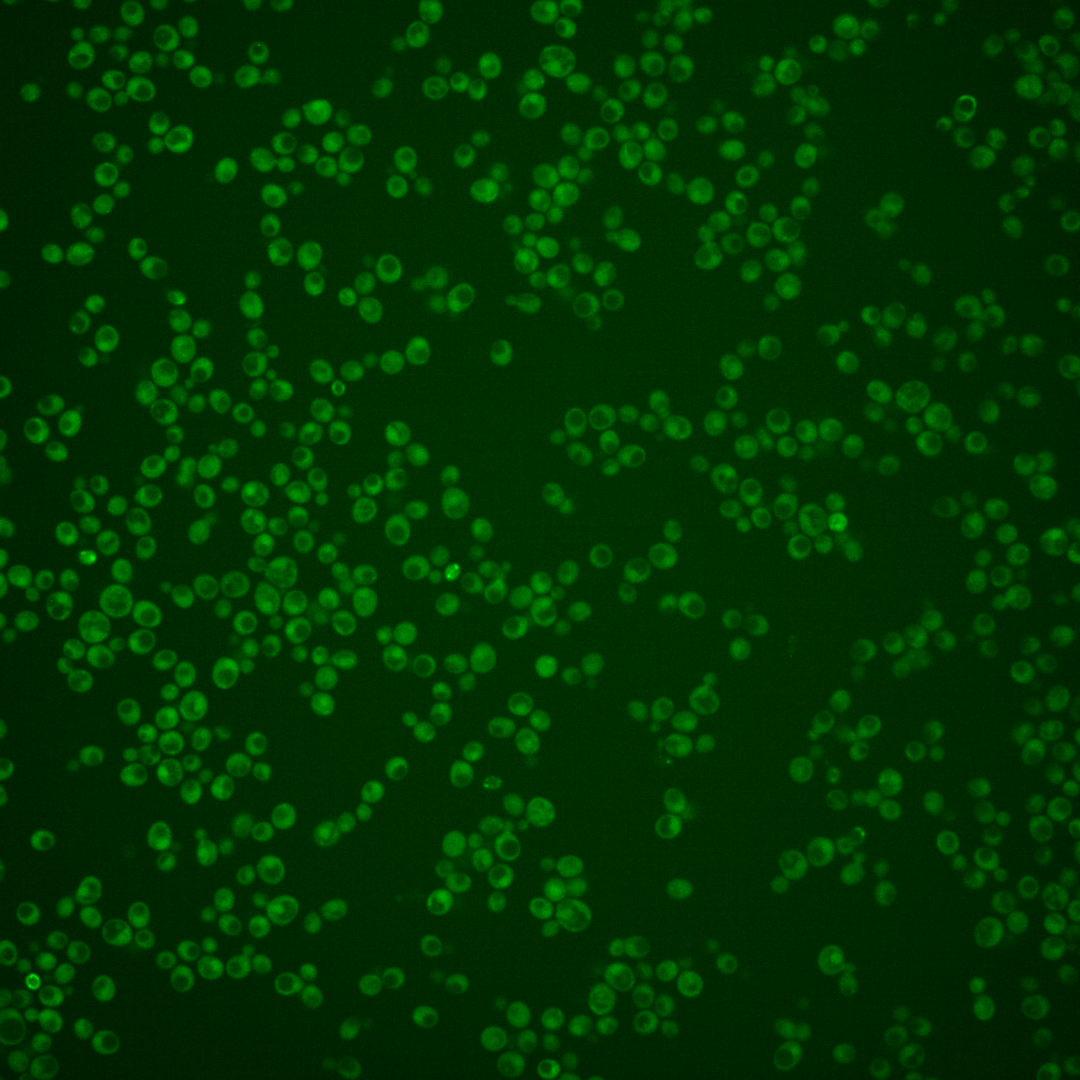
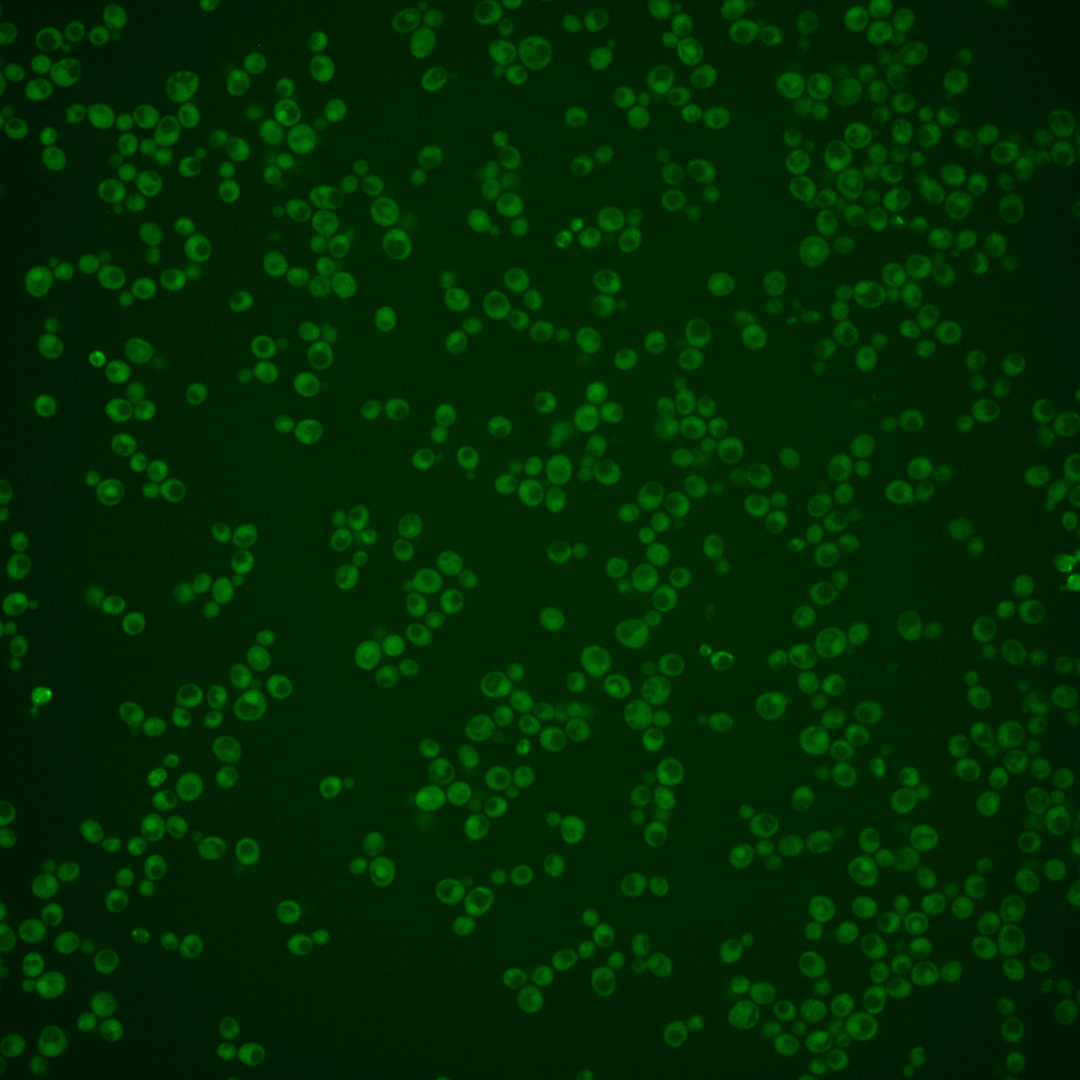
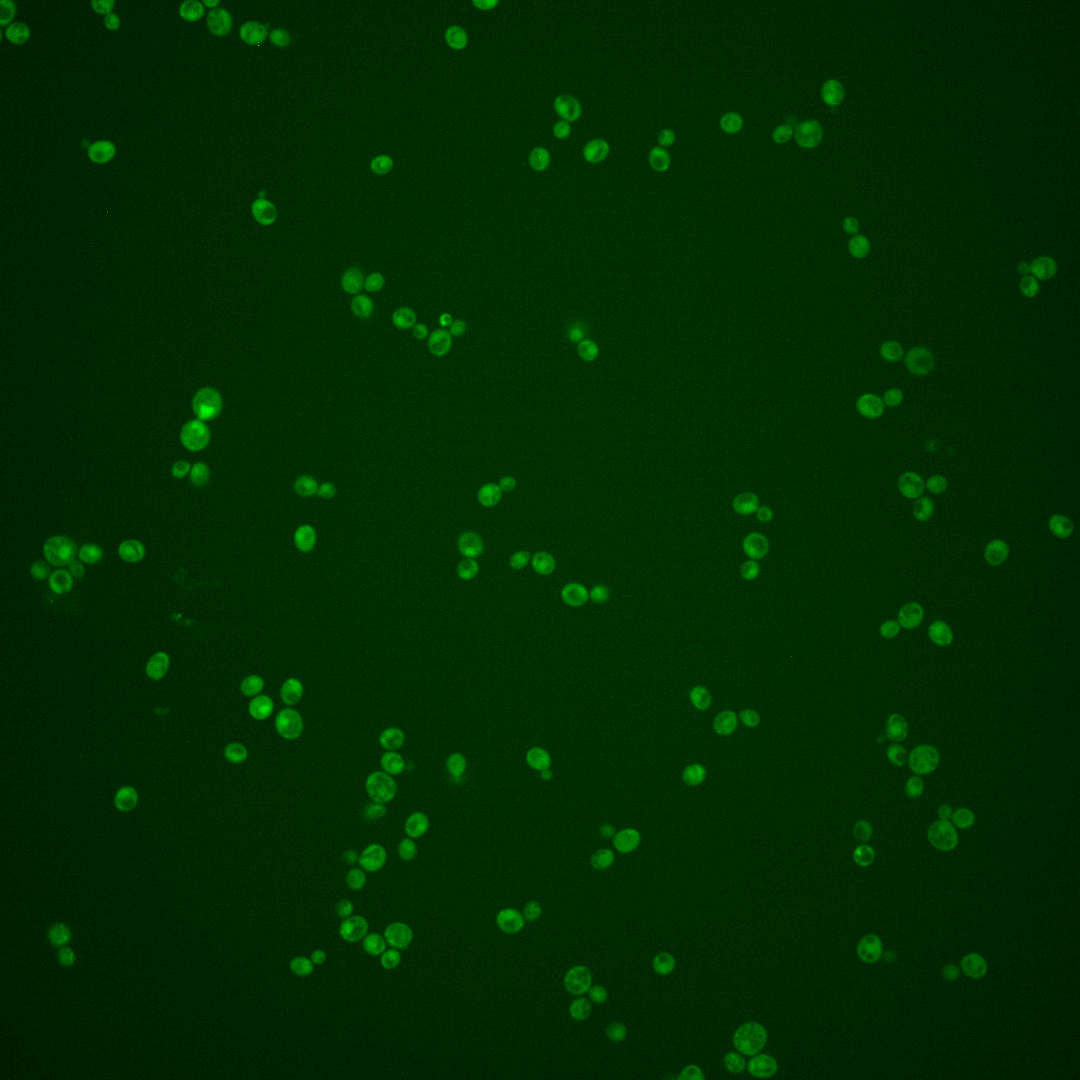
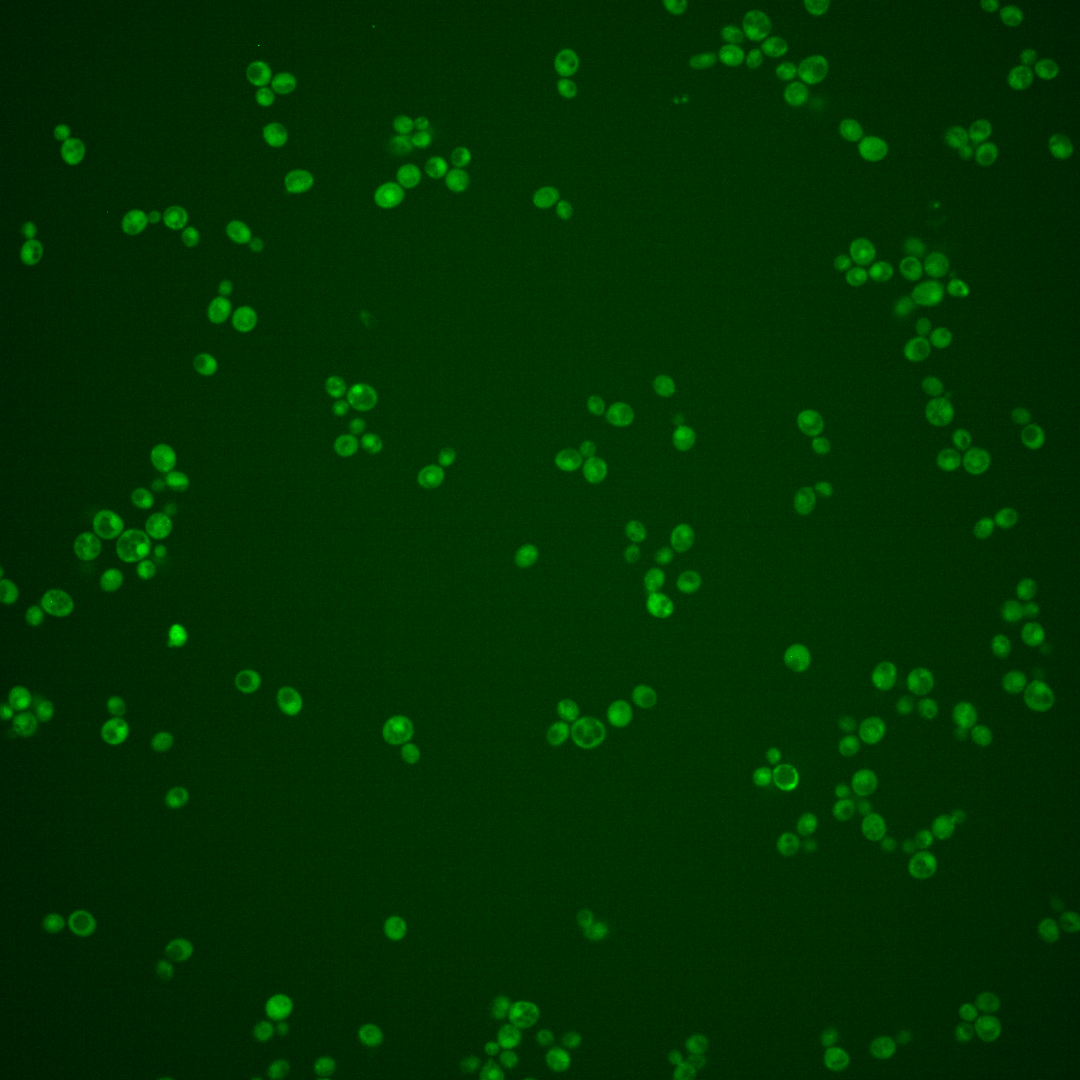

| Standard name | |
|---|---|
| Human Ortholog | |
| Description | Minor sphingoid long-chain base kinase; possibly involved in synthesis of long-chain base phosphates, which function as signaling molecules; LCB5 has a paralog, LCB4, that arose from the whole genome duplication |
Micrographs




















































































Sub-cellular Localization
Yeast GFP Assignment
Protein Abundance
Localization Change
External localization resources
| ensLOC | DeepLoc | |||||||||||||||||||||||
|---|---|---|---|---|---|---|---|---|---|---|---|---|---|---|---|---|---|---|---|---|---|---|---|---|
| Localization | WT1 | WT2 | WT3 | RAP60 | RAP140 | RAP220 | RAP300 | RAP380 | RAP460 | RAP540 | RAP620 | RAP700 | HU80 | HU120 | HU160 | rpd3Δ_1 | rpd3Δ_2 | rpd3Δ_3 | WT1 | WT2 | WT3 | AF100 | AF140 | AF180 |
| Cortical Patches | 0 | 0 | 0 | 0 | 0 | 0 | 0 | – | 0 | 0 | 0 | 0 | 0 | 0 | 0 | 0 | 0 | 0 | 1 | 0 | 4 | 0 | 3 | 1 |
| Bud | 0 | 0 | 0 | 0 | 0 | 1 | 1 | – | 2 | 0 | 1 | 2 | 0 | 0 | 0 | 0 | 0 | 0 | 0 | 0 | 3 | 0 | 5 | 2 |
| Bud Neck | 0 | 0 | 3 | 1 | 3 | 3 | 3 | – | 2 | 3 | 2 | 2 | 0 | 0 | 0 | 0 | 0 | 0 | 0 | 0 | 1 | 0 | 1 | 1 |
| Bud Site | 0 | 0 | 0 | 0 | 0 | 0 | 0 | – | 0 | 0 | 1 | 0 | 0 | 0 | 0 | 0 | 0 | 0 | – | – | – | – | – | – |
| Cell Periphery | 0 | 1 | 3 | 1 | 0 | 1 | 0 | – | 1 | 1 | 0 | 0 | 0 | 0 | 0 | 0 | 1 | 1 | 1 | 0 | 0 | 0 | 0 | 0 |
| Cytoplasm | 89 | 88 | 89 | 59 | 123 | 143 | 156 | – | 83 | 64 | 50 | 47 | 69 | 145 | 189 | 23 | 52 | 76 | 75 | 89 | 55 | 29 | 79 | 101 |
| Endoplasmic Reticulum | 0 | 1 | 1 | 1 | 1 | 3 | 1 | – | 1 | 0 | 0 | 1 | 2 | 0 | 1 | 4 | 4 | 3 | 2 | 0 | 1 | 1 | 4 | 2 |
| Endosome | 0 | 0 | 1 | 0 | 0 | 2 | 3 | – | 0 | 0 | 0 | 0 | 0 | 2 | 0 | 3 | 3 | 1 | 1 | 3 | 4 | 1 | 3 | 5 |
| Golgi | 0 | 1 | 0 | 1 | 0 | 0 | 0 | – | 0 | 1 | 0 | 0 | 0 | 2 | 2 | 0 | 2 | 2 | 1 | 3 | 4 | 0 | 3 | 2 |
| Mitochondria | 5 | 1 | 0 | 3 | 0 | 13 | 20 | – | 29 | 18 | 22 | 26 | 0 | 0 | 0 | 2 | 1 | 4 | 17 | 7 | 20 | 1 | 3 | 6 |
| Nucleus | 0 | 0 | 3 | 0 | 1 | 2 | 2 | – | 3 | 1 | 0 | 0 | 0 | 3 | 1 | 0 | 1 | 1 | 0 | 0 | 0 | 0 | 1 | 0 |
| Nuclear Periphery | 0 | 0 | 0 | 0 | 0 | 0 | 0 | – | 0 | 0 | 0 | 0 | 0 | 0 | 0 | 0 | 1 | 2 | 0 | 0 | 0 | 0 | 0 | 1 |
| Nucleolus | 1 | 0 | 0 | 0 | 0 | 0 | 0 | – | 0 | 1 | 2 | 0 | 0 | 0 | 0 | 1 | 1 | 0 | 0 | 0 | 0 | 0 | 0 | 0 |
| Peroxisomes | 0 | 0 | 0 | 0 | 0 | 1 | 0 | – | 0 | 0 | 0 | 0 | 0 | 0 | 0 | 0 | 0 | 0 | 0 | 0 | 0 | 0 | 0 | 0 |
| SpindlePole | 0 | 0 | 0 | 0 | 2 | 3 | 5 | – | 1 | 1 | 0 | 1 | 0 | 0 | 2 | 0 | 1 | 0 | 3 | 1 | 3 | 3 | 1 | 4 |
| Vac/Vac Membrane | 0 | 1 | 3 | 0 | 4 | 1 | 3 | – | 3 | 1 | 0 | 0 | 0 | 1 | 0 | 2 | 2 | 1 | 6 | 5 | 4 | 2 | 4 | 8 |
| Unique Cell Count | 93 | 92 | 96 | 62 | 129 | 160 | 172 | 107 | 81 | 64 | 67 | 71 | 151 | 194 | 28 | 60 | 83 | 114 | 118 | 113 | 41 | 119 | 144 | |
| Labelled Cell Count | 95 | 93 | 103 | 66 | 134 | 173 | 194 | 125 | 91 | 78 | 79 | 71 | 153 | 195 | 35 | 69 | 91 | 114 | 118 | 113 | 41 | 119 | 144 | |
Yeast GFP Assignment
Protein Abundance
| Screen | WT1 | WT2 | WT3 | RAP60 | RAP140 | RAP220 | RAP300 | RAP380 | RAP460 | RAP540 | RAP620 | RAP700 | HU80 | HU120 | HU160 | rpd3Δ_1 | rpd3Δ_2 | rpd3Δ_3 | AF100 | AF140 | AF180 |
|---|---|---|---|---|---|---|---|---|---|---|---|---|---|---|---|---|---|---|---|---|---|
| Mean Cell GFP Intensity (1e-4) | 3.3 | 4.2 | 5.2 | 5.4 | 6.3 | 5.0 | 5.2 | – | 3.6 | 4.0 | 3.2 | 3.7 | 5.1 | 5.9 | 5.2 | 5.8 | 7.8 | 7.1 | – | 5.8 | 5.5 |
| Std Deviation (1e-4) | 0.5 | 1.3 | 2.2 | 3.5 | 3.9 | 3.7 | 4.0 | – | 1.7 | 2.0 | 1.5 | 2.0 | 1.7 | 2.5 | 2.0 | 1.9 | 4.2 | 3.5 | – | 2.4 | 2.3 |
| Intensity Change (Log2) | – | – | – | 0.04 | 0.26 | -0.06 | -0.0 | – | -0.53 | -0.41 | -0.72 | -0.51 | -0.03 | 0.18 | -0.02 | 0.15 | 0.58 | 0.44 | – | 0.15 | 0.07 |
Localization Change
| Localization | RAP60 | RAP140 | RAP220 | RAP300 | RAP380 | RAP460 | RAP540 | RAP620 | RAP700 | HU80 | HU120 | HU160 | rpd3Δ_1 | rpd3Δ_2 | rpd3Δ_3 |
|---|---|---|---|---|---|---|---|---|---|---|---|---|---|---|---|
| Actin | – | – | – | – | – | – | – | – | – | – | – | – | – | – | – |
| Bud | – | – | – | – | – | – | – | – | – | – | – | – | – | – | – |
| Bud Neck | – | – | – | – | – | – | – | – | – | – | – | – | – | – | – |
| Bud Site | – | – | – | – | – | – | – | – | – | – | – | – | – | – | – |
| Cell Periphery | – | – | – | – | – | – | – | – | – | – | – | – | – | – | – |
| Cyto | – | – | – | – | – | – | – | – | – | – | – | – | – | – | – |
| Endoplasmic Reticulum | – | – | – | – | – | – | – | – | – | – | – | – | – | – | – |
| Endosome | – | – | – | – | – | – | – | – | – | – | – | – | – | – | – |
| Golgi | – | – | – | – | – | – | – | – | – | – | – | – | – | – | – |
| Mitochondria | – | – | – | – | – | – | – | – | – | – | – | – | – | – | – |
| Nuclear Periphery | – | – | – | – | – | – | – | – | – | – | – | – | – | – | – |
| Nuc | – | – | – | – | – | – | – | – | – | – | – | – | – | – | – |
| Nucleolus | – | – | – | – | – | – | – | – | – | – | – | – | – | – | – |
| Peroxisomes | – | – | – | – | – | – | – | – | – | – | – | – | – | – | – |
| SpindlePole | – | – | – | – | – | – | – | – | – | – | – | – | – | – | – |
| Vac | – | – | – | – | – | – | – | – | – | – | – | – | – | – | – |
| Cortical Patches | – | – | – | – | – | – | – | – | – | – | – | – | – | – | – |
| Cytoplasm | – | – | – | – | – | – | – | – | – | – | – | – | – | – | – |
| Nucleus | – | – | – | – | – | – | – | – | – | – | – | – | – | – | – |
| Vacuole | – | – | – | – | – | – | – | – | – | – | – | – | – | – | – |
External localization resources
Images






























Protein Concentration and Protein Localization Data
| R1 | R2 | R3 | ||||||||||||||||
|---|---|---|---|---|---|---|---|---|---|---|---|---|---|---|---|---|---|---|
| G1 Pre-START | G1 Post-START | S/G2 | Metaphase | Anaphase | Telophase | G1 Pre-START | G1 Post-START | S/G2 | Metaphase | Anaphase | Telophase | G1 Pre-START | G1 Post-START | S/G2 | Metaphase | Anaphase | Telophase | |
| Concentration | -1.5373 | -1.5088 | -1.7593 | -1.9525 | -2.0626 | -1.0905 | -0.845 | -0.5756 | -0.6156 | 0.0178 | -0.7346 | -0.6158 | -0.1235 | -0.954 | -1.1184 | -0.2618 | -0.5496 | -0.886 |
| Actin | 0.0367 | 0.0047 | 0.0027 | 0.0512 | 0.0052 | 0.0285 | 0.0118 | 0.0068 | 0.0012 | 0.0023 | 0.0098 | 0.001 | 0.0722 | 0.0081 | 0.036 | 0.0418 | 0.0849 | 0.0223 |
| Bud | 0.0009 | 0.0001 | 0.0026 | 0.0004 | 0.0045 | 0.0003 | 0.0005 | 0.0005 | 0.0025 | 0.0049 | 0.0007 | 0.0001 | 0.0013 | 0.0042 | 0.0071 | 0.0009 | 0.0031 | 0.001 |
| Bud Neck | 0.007 | 0.0005 | 0.0006 | 0.0043 | 0.001 | 0.0007 | 0.009 | 0.0019 | 0.0045 | 0.026 | 0.0005 | 0.0016 | 0.0032 | 0.0009 | 0.005 | 0.001 | 0.0112 | 0.0011 |
| Bud Periphery | 0.0015 | 0.0001 | 0.0137 | 0.0008 | 0.0085 | 0.0003 | 0.0008 | 0.0016 | 0.0024 | 0.0069 | 0.0025 | 0.0001 | 0.004 | 0.0086 | 0.0074 | 0.0014 | 0.0101 | 0.0031 |
| Bud Site | 0.0107 | 0.0127 | 0.0003 | 0.0045 | 0.0016 | 0.0006 | 0.0212 | 0.0095 | 0.0142 | 0.0816 | 0.0019 | 0.0012 | 0.0028 | 0.023 | 0.0241 | 0.0031 | 0.0073 | 0.0006 |
| Cell Periphery | 0.0009 | 0.0002 | 0.0002 | 0.0006 | 0.0005 | 0.0002 | 0.0004 | 0.0006 | 0.0004 | 0.0019 | 0.0003 | 0.0001 | 0.0008 | 0.0006 | 0.0006 | 0.0003 | 0.0006 | 0.0001 |
| Cytoplasm | 0.0101 | 0.0145 | 0.0351 | 0.0094 | 0.0216 | 0.0732 | 0.0089 | 0.0145 | 0.0294 | 0.0111 | 0.0182 | 0.0177 | 0.0378 | 0.0374 | 0.0453 | 0.1167 | 0.0416 | 0.0698 |
| Cytoplasmic Foci | 0.02 | 0.0034 | 0.007 | 0.0097 | 0.024 | 0.0309 | 0.0344 | 0.002 | 0.0184 | 0.0174 | 0.0037 | 0.0141 | 0.0246 | 0.0135 | 0.0175 | 0.0127 | 0.0462 | 0.0068 |
| Eisosomes | 0.0007 | 0.0007 | 0.0005 | 0.0026 | 0.0003 | 0.0002 | 0.0005 | 0.0005 | 0.0003 | 0.0003 | 0.0003 | 0.0002 | 0.0009 | 0.0003 | 0.0004 | 0.0004 | 0.0006 | 0.0002 |
| Endoplasmic Reticulum | 0.0059 | 0.0009 | 0.0009 | 0.0008 | 0.0038 | 0.001 | 0.0009 | 0.0043 | 0.0041 | 0.0029 | 0.0004 | 0.0008 | 0.02 | 0.0012 | 0.0014 | 0.0059 | 0.0036 | 0.0015 |
| Endosome | 0.0333 | 0.0036 | 0.0058 | 0.0105 | 0.0692 | 0.0366 | 0.0237 | 0.0032 | 0.0022 | 0.0734 | 0.0045 | 0.005 | 0.037 | 0.0162 | 0.0103 | 0.0369 | 0.033 | 0.0049 |
| Golgi | 0.0113 | 0.0007 | 0.001 | 0.0097 | 0.0416 | 0.0369 | 0.0114 | 0.0009 | 0.0007 | 0.0187 | 0.0038 | 0.0012 | 0.0139 | 0.0022 | 0.006 | 0.0246 | 0.0215 | 0.0023 |
| Lipid Particles | 0.0127 | 0.0129 | 0.0125 | 0.0272 | 0.0063 | 0.0276 | 0.0202 | 0.0007 | 0.0016 | 0.0101 | 0.0227 | 0.0122 | 0.0165 | 0.011 | 0.0026 | 0.0183 | 0.0173 | 0.0013 |
| Mitochondria | 0.0058 | 0.001 | 0.0009 | 0.0378 | 0.1138 | 0.0481 | 0.0163 | 0.0007 | 0.0125 | 0.0068 | 0.0101 | 0.0105 | 0.0088 | 0.0025 | 0.0081 | 0.0145 | 0.0045 | 0.0019 |
| None | 0.7926 | 0.9413 | 0.907 | 0.8157 | 0.6659 | 0.6807 | 0.7985 | 0.9484 | 0.8893 | 0.6569 | 0.9099 | 0.9093 | 0.685 | 0.8531 | 0.8075 | 0.6987 | 0.6275 | 0.8669 |
| Nuclear Periphery | 0.0109 | 0.0002 | 0.0004 | 0.0005 | 0.0021 | 0.0043 | 0.0014 | 0.0007 | 0.0013 | 0.0045 | 0.0008 | 0.0061 | 0.0249 | 0.0014 | 0.0012 | 0.005 | 0.0212 | 0.0043 |
| Nucleolus | 0.0063 | 0.0001 | 0.0038 | 0.0005 | 0.0045 | 0.0005 | 0.0024 | 0.0004 | 0.0012 | 0.0095 | 0.0005 | 0.0015 | 0.001 | 0.0011 | 0.0005 | 0.0002 | 0.0012 | 0.0004 |
| Nucleus | 0.0109 | 0.0001 | 0.0006 | 0.0003 | 0.0027 | 0.0006 | 0.0022 | 0.0006 | 0.0026 | 0.0099 | 0.0004 | 0.0068 | 0.014 | 0.0013 | 0.0018 | 0.0014 | 0.0027 | 0.0013 |
| Peroxisomes | 0.0093 | 0.0014 | 0.0014 | 0.0095 | 0.0042 | 0.0163 | 0.0244 | 0.0001 | 0.0024 | 0.0025 | 0.0067 | 0.0014 | 0.0177 | 0.0035 | 0.0126 | 0.0089 | 0.0539 | 0.0008 |
| Punctate Nuclear | 0.0047 | 0.0002 | 0.0007 | 0.0022 | 0.0091 | 0.0103 | 0.0056 | 0.0007 | 0.0072 | 0.0183 | 0.0009 | 0.0078 | 0.0053 | 0.0074 | 0.0025 | 0.0042 | 0.0044 | 0.0085 |
| Vacuole | 0.0059 | 0.0003 | 0.0019 | 0.0012 | 0.0057 | 0.0015 | 0.0048 | 0.0011 | 0.001 | 0.0293 | 0.001 | 0.0005 | 0.0048 | 0.002 | 0.0015 | 0.0019 | 0.0021 | 0.0007 |
| Vacuole Periphery | 0.0018 | 0.0001 | 0.0003 | 0.0007 | 0.004 | 0.0009 | 0.0007 | 0.0002 | 0.0004 | 0.0048 | 0.0006 | 0.0008 | 0.0035 | 0.0005 | 0.0007 | 0.0012 | 0.0017 | 0.0003 |
Sequencing Data
| R1 | R2 | |||||||||
|---|---|---|---|---|---|---|---|---|---|---|
| G1 Post-START | S/G2 | Metaphase | Anaphase | Telophase | G1 Post-START | S/G2 | Metaphase | Anaphase | Telophase | |
| Gene Expression | 15.5033 | 12.4253 | 15.6032 | 13.7842 | 13.1694 | 13.3575 | 19.2072 | 20.2199 | 19.8325 | 18.1899 |
| Translational Efficiency | 0.6341 | 0.9679 | 0.478 | 0.6669 | 0.7086 | 0.9035 | 0.727 | 0.7175 | 0.7101 | 0.8023 |
Hit Data
| Dataset | Hit |
|---|---|
| Protein Concentration | ✘ |
| Protein Localization | ✘ |
| Gene Expression | ✘ |
| Translational Efficiency | ✘ |
Endocytosis
| Temp | Actin Patch (Sac6-tdTomato) | Cortical Patch (Sla1-GFP) | Late Endosome (Snf7-GFP) | Vacuole (Vph1-GFP) |
|---|---|---|---|---|
| 37℃ | ||||
| RT |
Cell Cycle Omics
CYCLoPs (Lcb5-GFP)
| Gene / Allele | Actin Patch (Sac6-tdTomato) | Cortical Patch (Sla1-GFP) | Late Endosome (Snf7-GFP) | Vacuole (Sac6-tdTomato) |
|---|
| Gene | Images |
|---|
| Gene | Images |
|---|
Images are not yet available
Images are not yet available